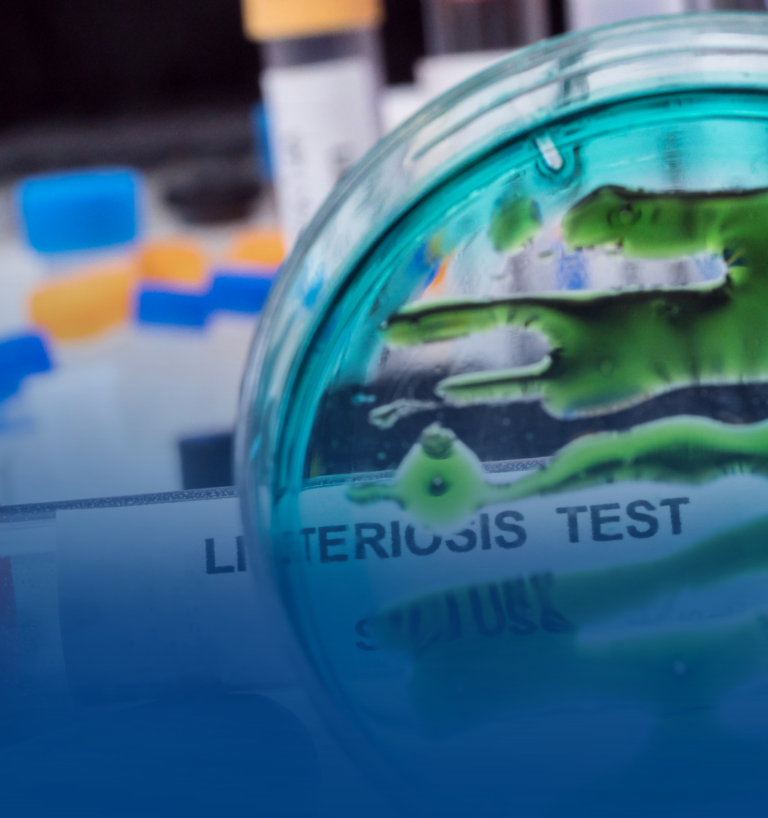
Listeria monocytogenes: un desafío permanente para las plantas de alimentos listos para el consumo

Actualidad
Tendencias y noticias de la industria
-

Preparando el plan de capacitación 2026: recomendaciones prácticas para las empresas
El fin de año es más que cierre de tareas, revisión de indicadores y planificación presupuestaria. También es el momento ideal para revisar la cómo estuvo el plan de capacitación […]
-
Listeria monocytogenes: un desafío permanente para las plantas de alimentos listos para el consumo
En la industria de alimentos listos para el consumo (RTE), Listeria monocytogenes continúa destacándose como uno de los patógenos más complejos de gestionar. Su capacidad de adaptación, su presencia ubicua […]
-

Programa de Monitoreo Ambiental: la herramienta estratégica que define la inocuidad moderna en plantas de alimentos
La inocuidad alimentaria dejó de ser un concepto basado únicamente en limpieza visible, cumplimiento documental o buenas intenciones operativas. Hoy, la gran diferencia entre una planta que controla sus riesgos […]
-

Proteger el negocio de exportación de berries en América Latina es un buen negocio
Para los productores de berries en América Latina, la implementación rigurosa de Buenas Prácticas Agrícolas (BPA) y Buenas Prácticas de Manufactura (BPM) para prevenir la contaminación por virus (p. ej. […]
-

Transición estratégica hacia la versión 7 de FSSC 22000: una mirada al futuro de la seguridad alimentaria
La industria alimentaria enfrenta desafíos cada vez más complejos: cadenas de suministro globales, nuevas regulaciones y exigencias de sostenibilidad. En este contexto, la Foundation FSSC anunció el desarrollo de la […]
-

Inocuidad alimentaria: ciencia, cultura y colaboración para un Chile más seguro
Estamos muy contentos de compartir que 360GMS GROUP, con el patrocinio de ACHIPIA, Pensar Agro Chile y la Universidad Santo Tomás con el auspicio de Neogen organizó el Encuentro de […]
